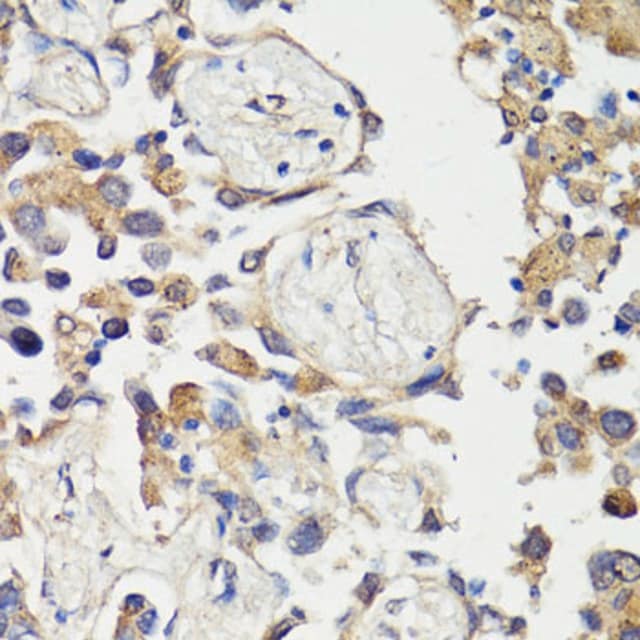

您的位置:首页 > 产品中心 > Anti-c-Fos antibody produced in rabbit
产品别名
Anti-c-Fos antibody produced in rabbit
FOS
C-FOS
AP-1
p55
产品性质
| biological source【生物来源】 | rabbit |
| Quality Level【质量水平】 | 100 |
| antibody form【抗体形式】 | affinity isolated antibody |
| antibody product type | primary antibodies |
| clone【克隆】 | polyclonal |
| form【形式】 | buffered aqueous solution |
| mol wt【分子量】 | 28 36 40 |
| species reactivity | human, mouse, rat |
| concentration【浓度】 | 0.94 mg/ml |
| technique(s) | immunofluorescence: 1:50-1:200 immunohistochemistry: 1:50-1:200 western blot: 1:500-1:2000 |
| UniProt accession no.【UniProt登记号】 | P01100 |
| shipped in【运输】 | wet ice |
| storage temp.【储存温度】 | −20℃ |
| Gene Information | human ... FOS(2353) |
基本信息
| General description【一般描述】 | The Fos gene family consists of 4 members: FOS, FOSB, FOSL1, and FOSL2. These genes encode leucine zipper proteins that can dimerize with proteins of the JUN family, thereby forming the transcription factor complex AP-1. As such, the FOS proteins have been implicated as regulators of cell proliferation, differentiation, and transformation. In some cases, expression of the FOS gene has also been associated with apoptotic cell death. |
| Immunogen【免疫原】 | Recombinant fusion protein containing a sequence corresponding to amino acids 211-380 of human c-Fos (NP_005243.1). |
| Physical form【外形】 | PBS with 0.02% sodium azide,50% glycerol,pH7.3. |
产品说明
| Storage and Stability【储存及稳定性】 | Store at -20℃. Avoid freeze / thaw cycles. |
安全信息
| Storage Class Code【储存分类代码】 | 12 - Non Combustible Liquids |
| WGK | WGK 1 |